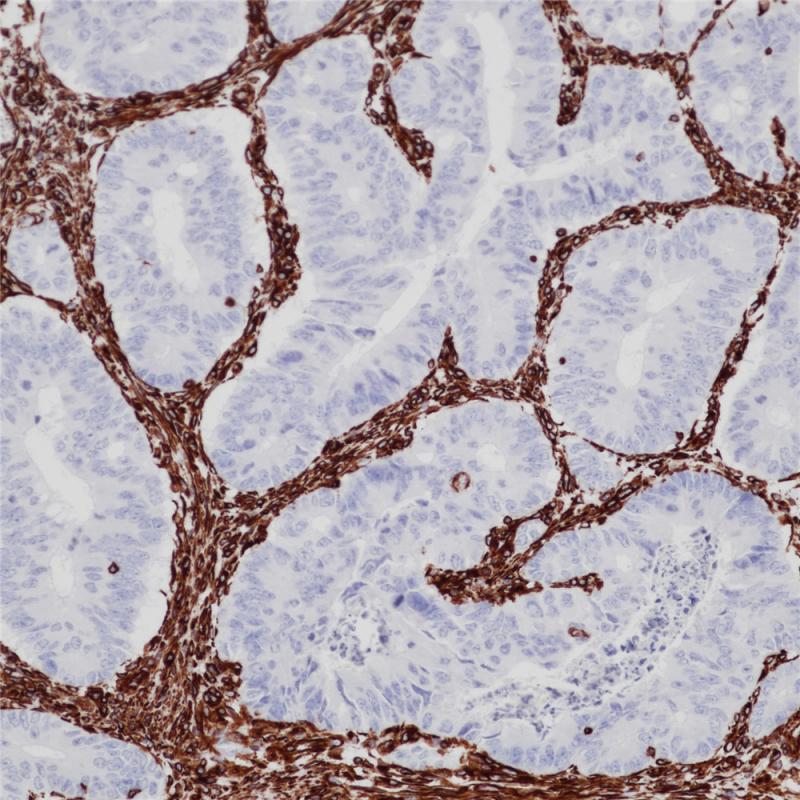
villin重组兔单克隆抗体

vimentin

anti-猪 vimentin 抗体 for 免疫萤光(if)
图片尺寸810x610
vimentin antibody
图片尺寸1280x960
vimentin波形蛋白myr1vim
图片尺寸2048x1536
vimentin regulates neuron morphology and mitochondria function
图片尺寸660x686
检测异倍体ctc中波形蛋白vimentin表达的特殊意义与临床应用
图片尺寸638x638
08 vimentin.png
图片尺寸1970x1438![anti-vimentin抗体[rv202] (ab8978)](https://imgs.wantubizhi.com/img/A1A61BAA66193547F3A6DD7D8EE527E91B3175EAD5A35894BF8FA6B274B2A05766E79A1C408D26D8B2E0FAC6B8774A3C35AEFC0DE361850153608743FEDB1A98C6DAE98047884F2D5AED97C8ED38F7AC6AFF9583A693BFC41E55F1816476892D)
anti-vimentin抗体[rv202] (ab8978)
图片尺寸600x600
免疫组化:肿瘤细胞vimentin(梭形细胞 )
图片尺寸2074x2220
selective mode of action of plumbagin through brc
图片尺寸567x824
expression of the mesenchymal cell marker vimentin in injured
图片尺寸1280x1064
villin重组兔单克隆抗体
图片尺寸800x800
vimentin 抗体 (vim)
图片尺寸810x610
恶性纤维组织细胞瘤肿瘤细胞胞质vimentin( )(envision二步法染色
图片尺寸1000x799
vimentin瘤细胞阳性(en vision法×20)
图片尺寸700x636
sphingomyelin synthase 1 regulates the epithelial62t
图片尺寸1913x2437
银染见网状纤维分布于梭形细胞之间并围绕血管腔隙; vimentin,erg
图片尺寸1181x945
mesonephric adenocarcinoma of the uterine corpus wi
图片尺寸472x630
marker_蛋白_高尔基体
图片尺寸720x2579
肿瘤抑制因子zdhhc1
图片尺寸1077x888
vimentin 波形蛋白vimentin 波形蛋白villin 微管素villin 微管素
图片尺寸639x450






![anti-vimentin抗体[rv202] (ab8978)](https://imgs.wantubizhi.com/img/A1A61BAA66193547F3A6DD7D8EE527E91B3175EAD5A35894BF8FA6B274B2A05766E79A1C408D26D8B2E0FAC6B8774A3C35AEFC0DE361850153608743FEDB1A98C6DAE98047884F2D5AED97C8ED38F7AC6AFF9583A693BFC41E55F1816476892D)














-1ug-malignant-melanoma.png)




![anti-vimentin抗体[rv202] (ab8978)](https://www.abcam.cn/ps/products/8/ab8978/Images/ab8978-277295-anti-vimentin-antibody-rv202-immunofluorescence.jpg)